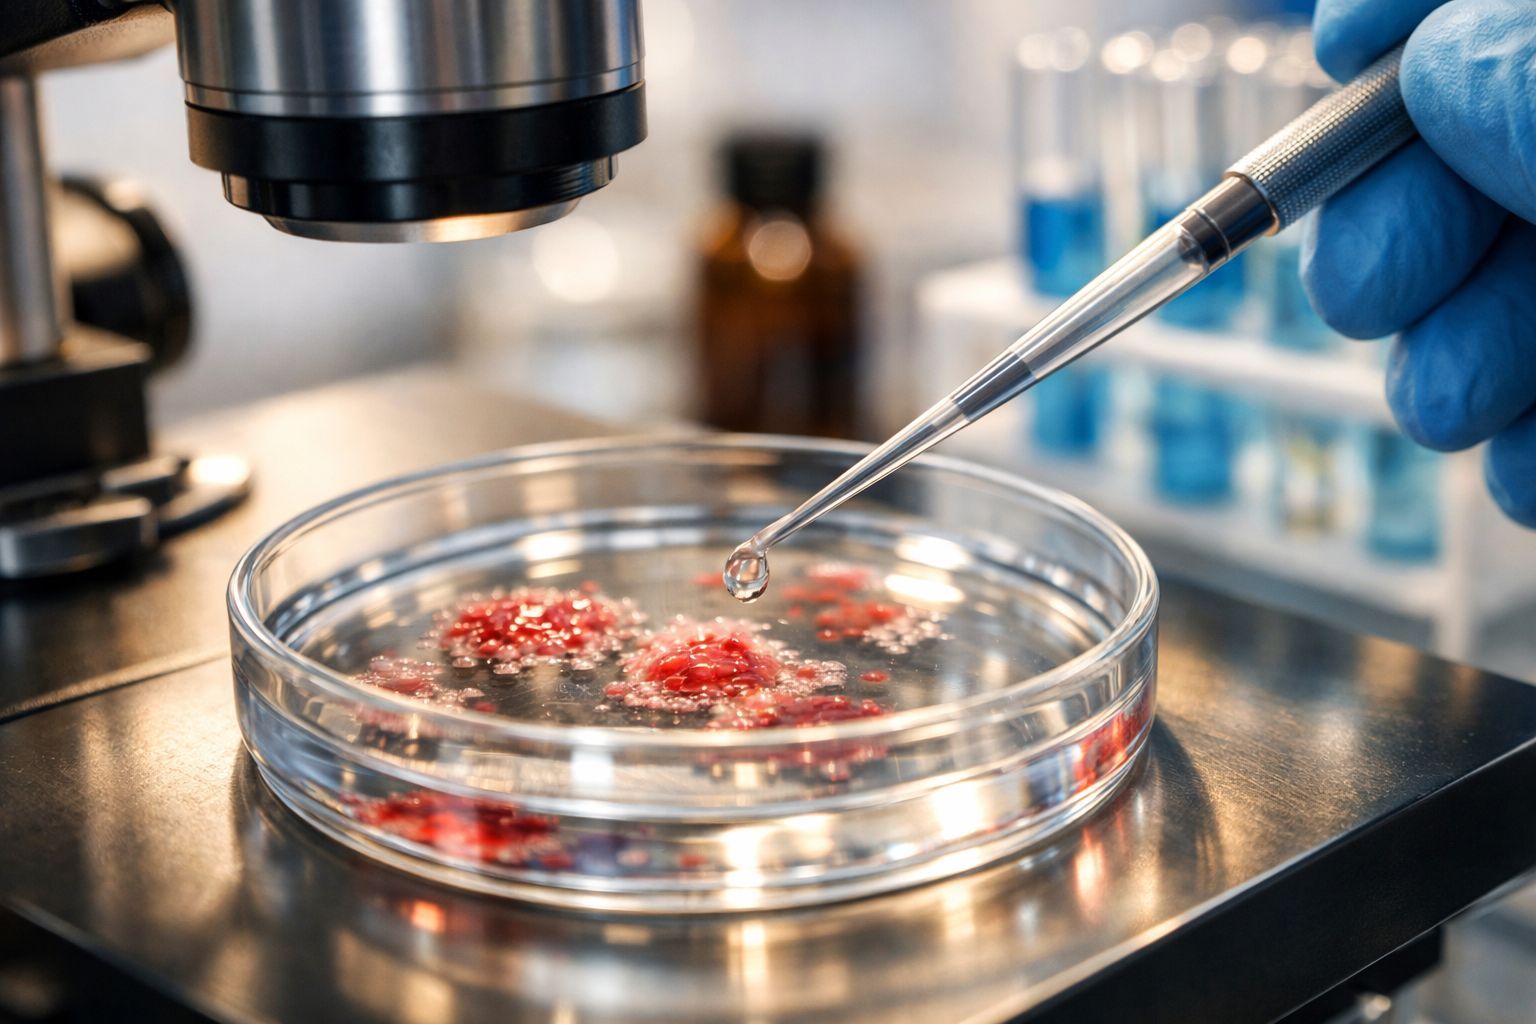

L’or noir : Ce fruit gorgé de vitamines qui régule la glycémie et la tension artérielle
Auteur: Mathieu Gagnon
Une baie aux promesses étonnantes

On entend souvent parler de super-aliments, mais celui-ci a quelque chose de particulier, presque mystérieux. Les baies du genre Aronia, qu’on appelle aussi parfois l’aronie noire ou black chokeberry en anglais, sont originaires d’Amérique du Nord et commencent sérieusement à faire parler d’elles. Pourquoi ? Eh bien, principalement pour leur teneur exceptionnellement élevée en composés polyphénoliques. Ce n’est pas juste un fruit de plus dans le panier ; ces substances chimiques naturelles sont associées à des bienfaits qui dépassent la simple nutrition de base.
Imaginez un instant que ce petit fruit puisse avoir des effets antioxydants capables de calmer les processus inflammatoires du corps… C’est tentant, non ? De plus en plus de gens se posent la question de la place de l’aronia dans nos repas quotidiens. L’idée est simple : voir si un fruit, somme toute assez modeste, pourrait soutenir nos modes de vie parfois un peu chaotiques. Récemment, des scientifiques se sont penchés sur une question précise : le jus d’aronia pourrait-il nous protéger contre les défis alimentaires liés au microbiome intestinal ? C’est un sujet passionnant qui mérite qu’on s’y attarde.
La science derrière l’aronia : Une protection robuste pour nos intestins
C’est là que les choses deviennent un peu plus techniques, mais restez avec moi, car c’est fascinant. Ce projet de recherche a été mené par le Dr Stephanie M. G. Wilson de l’Université d’État du Montana. Son équipe a voulu comprendre comment les bactéries de notre système digestif réagissent lorsque les baies d’aronia entrent en scène, surtout quand on mange mal… vous savez, ces périodes où notre alimentation est trop riche et risque d’augmenter l’inflammation. Pour ce faire, l’équipe a utilisé un modèle de souris avec des microbiomes intestinaux humains transplantés. Oui, vous avez bien lu : des microbiomes provenant de donneurs humains ayant différents niveaux d’inflammation.
Les résultats ? Le Dr Wilson a noté que « la supplémentation en aronia offrait une protection robuste » à la fin de l’étude. C’est quand même une affirmation forte. Concrètement, les scientifiques ont observé une augmentation des Eggerthellaceae, une famille de bactéries capable de traiter les polyphénols. Certaines données ont également lié la consommation d’aronie noire à des changements dans les métabolites, ce qui suggère une amélioration des barrières intestinales. En gros, ces changements indiquent que manger ou boire des produits à base d’aronia pourrait aider à garder notre système digestif plus équilibré pendant les périodes de stress alimentaire. C’est un peu comme donner un coup de pouce à nos microbes face à un régime riche en graisses.
Une nutrition personnalisée et des bienfaits variés

Il faut bien comprendre que l’inflammation peut survenir quand on mange des aliments gras ou sucrés pendant de longues périodes. Mais nous ne sommes pas tous égaux face à cela. Les chercheurs soulignent que le microbiome unique de chaque personne pourrait déterminer sa capacité d’adaptation. Les bienfaits de l’aronia peuvent donc varier d’une personne à l’autre, selon l’écologie intestinale de chacun et son état de santé général. C’est ce qu’on appelle la nutrition personnalisée. D’ailleurs, l’étude a montré quelque chose d’intrigant : pour ceux qui portent déjà un ensemble de bactéries intestinales orientées vers une inflammation plus faible, les avantages de l’ajout d’aronia pourraient être plus visibles. Les souris avec des microbiomes de donneurs à faible inflammation étaient plus résilientes face au régime riche en graisses, et l’aronia semblait protéger ce groupe encore davantage.
Mais ce n’est pas tout. D’autres travaux publiés indiquent que l’aronia n’est pas seulement une source d’antioxydants ; il pourrait aussi être lié à des niveaux de glucose plus sains et à une meilleure fonction cardiaque. La présence d’anthocyanes et d’autres substances phénoliques pourrait expliquer comment ce fruit influence des voies complexes liées au métabolisme. Traditionnellement, on l’utilise dans des jus, des confitures et des poudres. Sa saveur est acidulée, ce qui ne plaît pas à tout le monde au premier abord, mais c’est facile à mélanger. On le trouve souvent en épicerie sous forme de mélanges de jus, de concentrés ou séché. Vous pouvez l’ajouter à des smoothies ou des desserts sans tout chambouler.
Conclusion : Un avenir prometteur pour notre santé

La recherche continue d’évaluer quelle quantité d’aronia est idéale pour nous, les humains, car la dose peut varier considérablement. Dans certains essais cliniques, des individus ont même connu des avantages potentiels contre l’obésité, en plus d’améliorations des défenses naturelles du corps. Ces premières observations ouvrent la voie à des enquêtes plus approfondies. L’aronia pourrait contenir des ingrédients spéciaux qui renforcent la capacité de l’intestin à faire face au stress.
Bien sûr, ce n’est pas une solution miracle, et les résultats différeront d’une personne à l’autre. Cependant, son potentiel va au-delà de la simple fourniture d’antioxydants : il peut se connecter aux microbes intestinaux de manière à soutenir un équilibre sain. L’intérêt pour l’aronia ne cesse de croître, et ces découvertes, publiées dans la revue Frontiers, laissent entrevoir un chemin fructueux pour les études futures. C’est peut-être le moment d’essayer ce petit fruit noir, qu’en pensez-vous ?
Selon la source : earth.com
Ce contenu a été créé avec l’aide de l’IA.